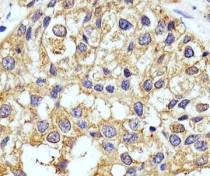

ARG55566
anti-Cathepsin D antibody
anti-Cathepsin D antibody for ICC/IF,IHC-Formalin-fixed paraffin-embedded sections,Western blot and Human
Cancer antibody; Cell Biology and Cellular Response antibody; Neuroscience antibody; Signaling Transduction antibody

1
Overview
| Product Description | Rabbit Polyclonal antibody recognizes Cathepsin D |
|---|---|
| Tested Reactivity | Hu |
| Tested Application | ICC/IF, IHC-P, WB |
| Host | Rabbit |
| Clonality | Polyclonal |
| Isotype | IgG |
| Target Name | Cathepsin D |
| Antigen Species | Human |
| Immunogen | KLH-conjugated synthetic peptide from Human Cathepsin D. |
| Conjugation | Un-conjugated |
| Alternate Names | CPSD; EC 3.4.23.5; HEL-S-130P; CLN10; Cathepsin D |
Application Instructions
| Application Suggestion |
|
||||||||
|---|---|---|---|---|---|---|---|---|---|
| Application Note | * The dilutions indicate recommended starting dilutions and the optimal dilutions or concentrations should be determined by the scientist. |
Properties
| Form | Liquid |
|---|---|
| Purification | Purification with Protein A and immunogen peptide. |
| Buffer | PBS and 0.09% (W/V) Sodium azide |
| Preservative | 0.09% (W/V) Sodium azide |
| Storage Instruction | For continuous use, store undiluted antibody at 2-8°C for up to a week. For long-term storage, aliquot and store at -20°C or below. Storage in frost free freezers is not recommended. Avoid repeated freeze/thaw cycles. Suggest spin the vial prior to opening. The antibody solution should be gently mixed before use. |
| Note | For laboratory research only, not for drug, diagnostic or other use. |
Bioinformation
| Database Links | |
|---|---|
| Gene Symbol | CTSD |
| Gene Full Name | cathepsin D |
| Background | This gene encodes a lysosomal aspartyl protease composed of a dimer of disulfide-linked heavy and light chains, both produced from a single protein precursor. This proteinase, which is a member of the peptidase C1 family, has a specificity similar to but narrower than that of pepsin A. Transcription of this gene is initiated from several sites, including one which is a start site for an estrogen-regulated transcript. Mutations in this gene are involved in the pathogenesis of several diseases, including breast cancer and possibly Alzheimer disease. [provided by RefSeq, Jul 2008] |
| Function | Acid protease active in intracellular protein breakdown. Involved in the pathogenesis of several diseases such as breast cancer and possibly Alzheimer disease. [UniProt] |
| Cellular Localization | Lysosome. Melanosome. Secreted, extracellular space. Note=Identified by mass spectrometry in melanosome fractions from stage I to stage IV. In aortic samples, detected as an extracellular protein loosely bound to the matrix (PubMed:20551380). |
| Research Area | Cancer antibody; Cell Biology and Cellular Response antibody; Neuroscience antibody; Signaling Transduction antibody |
| Calculated MW | 45 kDa |
| PTM | N- and O-glycosylated. Undergoes proteolytic cleavage and activation by ADAM30. As well as the major heavy chain which starts at Leu-169, 2 minor forms starting at Gly-170 and Gly-171 have been identified (PubMed:1426530). An additional form starting at Ala-168 has also been identified (PubMed:27333034). |
Images (3) Click the Picture to Zoom In
-
ARG55566 anti-Cathepsin D antibody WB image
Western blot: 20 µg of MCF7 cell lysates stained with ARG55566 anti-Cathepsin D antibody at 1:1000 dilution.
-
ARG55566 anti-Cathepsin D antibody ICC/IF image
Immunofluorescence: HepG2 cells stained with ARG55566 anti-Cathepsin D antibody (green) at 1:25 dilution. Cytoplasmic actin was counterstained with Alexa Fluor® 555 conjugated with Phalloidin (red).
-
ARG55566 anti-Cathepsin D antibody IHC-P image
Immunohistochemistry: Paraffin-embedded Human breast carcinoma section stained with ARG55566 anti-Cathepsin D antibody at 1:25 dilution.
Customer's Feedback